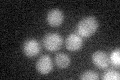
YIR025W
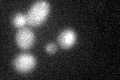
YIR025W
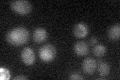
YIR025W

View description
Subunit of the anaphase-promoting complex (APC); necessary for maintaining sister chromatid cohesion in prophase I of meiosis by inhibiting premature ubiquitination and subsequent degradation of substrates by the APC(Ama1) ubiquitin ligase
Localization:
Intensity:
Fold change:
Significance:
-
C’ GFP library in SD
below threshold15.38 -
N' NOP1pr-GFP in SD

nucleus34.7438 -
N' TEF2pr-mCherry in SD

nucleus15.1683 -
N' NATIVEpr-GFP in SD

below threshold21.4849 -
N' TEF2pr-VC and Cyto-VN in SD

below threshold22.3532 -
C’ GFP library in SD+DTT
cytosol17.451.13No -
C’ GFP library in SD+H2O2

cytosol19.351.25No -
C’ GFP library in Starvation Media
cytosol22.641.47No -
C’ GFP library on the background of Pup2-DaMP

below threshold -
C’ GFP library on the background of CCT mutant

below threshold16.0991.0463No
